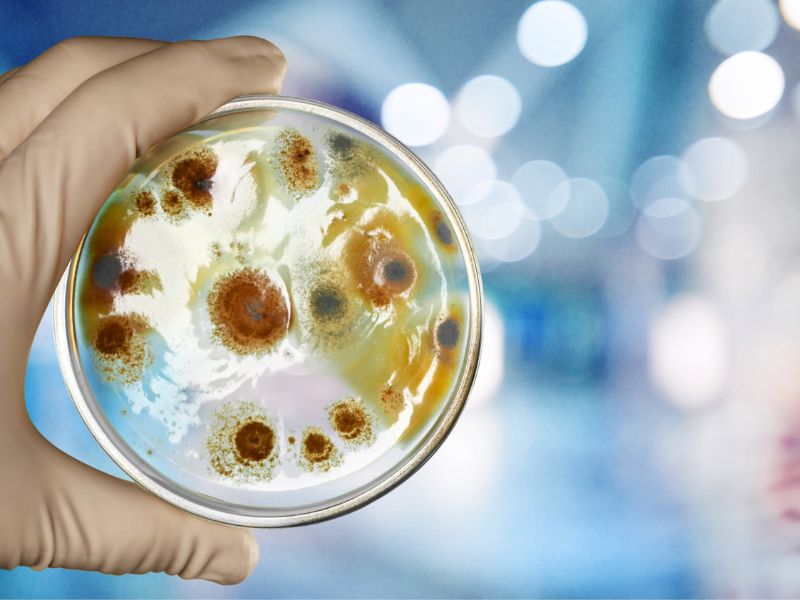
gyógyszerrezisztens gomba

Életmód
Itt az újabb veszély, támadnak a gyógyszerrezisztens gombák
A kutatók aggódnak amiatt, hogy a gombák alkalmazkodnak az emberi testhőmérséklethez. A gyógyszerrezisztens gombák összefüggésbe hozhatók az éghajlatváltozással, de a tudósok körében vita van erről.
Minden alkalommal, amikor a levegőn sétálunk, belélegezzük a gombaspórákat. A Földön rengeteg gombás kórokozó létezik, de szerencsére csak körülbelül 20 faj okoz fertőzést az emberben. Ennek az az oka, hogy immunrendszerünk hatékonyan véd meg minket a gombás betegségektől, és a testünk hőmérséklete túl magas a legtöbb gombafaj számára. Azonban támadnak a gyógyszerrezisztens gombák.
Egy új tanulmány azonban arra utal, hogy egyes gombás kórokozók úgy fejlődnek, hogy képesek megfertőzni az embereket. A kutatók úgy vélik, hogy ez összefüggésbe hozható az éghajlatváltozással. A tanulmány szerzői a Nature Microbiology folyóiratban megjelent cikkükben azt írták, hogy „az új gombás kórokozók veszélyét és jelentőségét komolyan alábecsülik manapság”. A kutatók 2009 és 2019 között 98 kínai kórház gombás fertőzéseinek feljegyzéseit vizsgálták át. Két olyan beteget találtak, akik olyan gombák csoportjával fertőződtek meg, amelyek korábban nem okoztak emberi betegségeket – írja a dw.com.
A gyógyszerrezisztens gombák alkalmazkodnak az emberi testhőmérséklethez
Laboratóriumi vizsgálatok során a kutatók megállapították, hogy ezek a gombák képesek megfertőzni az immunhiányos egereket, ami arra utal, hogy a csökkent immunrendszerű emberekben is kárt tehetnek, már közöttünk vannak a gyógyszerrezisztens gombák.
Az emlősök általában védettek a gombás fertőzésekkel szemben, mivel a 37°C-os testhőmérsékletünk túl magas a legtöbb gombafaj számára. A feljegyzések alapján azonban a kutatók azt találták, hogy az R. fluvialis és R. nylandii gombafajok jól tolerálják a magas hőmérsékletet. Sőt, a 37°C-os hőség megnövelte a gombatelepek mutációinak arányát a hűvösebb, 25°C-os hőmérséklethez képest. Ennek eredményeként a gombák gyógyszerrezisztensek a gombaellenes gyógyszerekkel szemben.
Az éghajlatváltozás okozza a gombák mutációját?
A tanulmány szerzői úgy vélik, hogy a globális felmelegedés hatására a gombás kórokozók gyógyszerrezisztenciát és virulenciát – vagyis betegségeket okozó képességet – fejlesztenek ki.
Más tanulmányok kimutatták, hogy egyes gyógyszerrezisztens gombák magasabb hőmérsékleten is növekedhetnek, mint néhány évtizeddel ezelőtt. Azonban „hiányzik a közvetlen bizonyítékunk arra vonatkozóan, hogy ez a két megfigyelés összefügg, és további kutatásokra van szükség” – mondta Toni Gabaldón, a spanyolországi barcelonai Biomedicina Kutatóintézet evolúciós biológusa.
Jatin Vyas orvos-tudós, aki a Harvardon gombakórokozókra specializálódott, nem volt meggyőződve arról, hogy a klímaváltozás volt az oka annak, hogy a gombák magasabb testhőmérsékleten fejlődtek ki. Vyas szerint fennáll a veszélye a gyógyszerrezisztens gombás kórokozók globális elterjedésének, mivel Spanyolországban, Portugáliában és Kanadában is kimutatták őket.
(via)
Újabb Covid-hullám söpör végig a világon, itt megtudhatod, mennyire veszélyes az új variáns.
Hozzászólás küldéséhez be kell jelentkezni.













